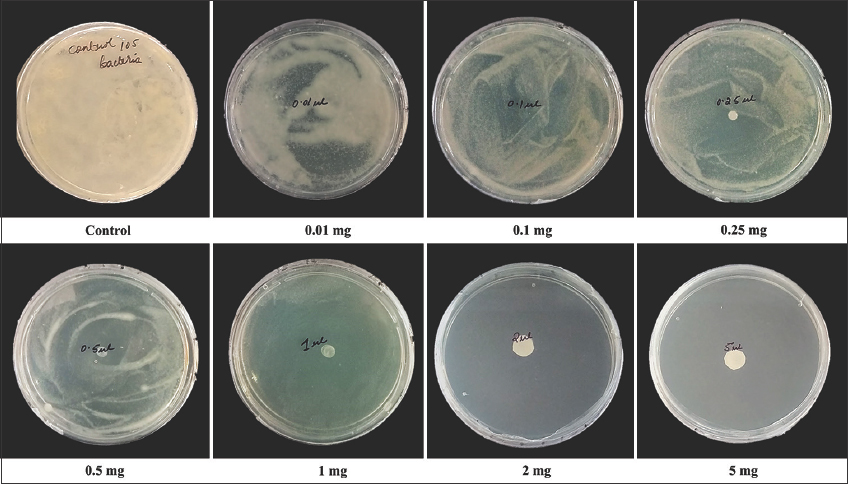

1. INTRODUCTION
Garlic (Allium sativum [L.]) is a widely used foodstuff that has been acclaimed over a period of 1000 years for its beneficial contribution to human health. According to worldwide trends, it has been used for therapeutic purposes and has potential for further expansion of its beneficial properties. On the flipside, its strong odor and fragrance have inspired a myriad of food delights as well as natural remedies for a wide range of health concern [1,2]. Its insightful qualities are rooted in amazing sulfur chemical properties and provide a raising diversity of sulfur effective compounds through different extraction procedures [3]. Although, with the rapid advancement of scientific research, different activities of garlic clove products have been established, many activities are not yet to be established for treating human acute and chronic diseases [4]. Consistent with earlier research, there is reason to believe that garlic components improve different human associated diseases. In addition, preclinical evidence suggests that garlic constituents may help to improve cardiovascular and cancer diseases [5]. On the other hand, essential oils also play a key role in promising pharmaceutical alternative and conventional therapy for related purposes [6-8]. In contrary to antimicrobial drugs, inhalation immunotherapy of volatile oil employed in health-care system to alleviate acute and chronic bronchitis-related disorders [9]. According to epidemiological research and randomized trials, garlic essential oil (GEO) has shown diverse pharmacological effects that are closely connected to its distinct active components [10]. Indeed, the efficacy of GEO has also been identified against some enteric bacterial stains, utilizing liquid, and disc volatilization approaches [11]. Altogether, GEO holds a promising future toward antibiotic remedies and conventional medicine for comparable objectives [9].
Notably, Mycobacterium tuberculosis, the causative agent of tuberculosis (TB), develops mainly pulmonary infections, although extrapulmonary infections are also found. The constantly growing antibiotic resistance strains of M. tuberculosis outlined as serious threat to community well-being as well as impacts on developed and developing countries [12]. According to the contemporary World Health Organization database 2021, there is a global incidence of 10 million affected individuals with tuberculosis infection that lead to 1.5 million deaths worldwide in 2020 [13]. The lipid rich surface layer makes this bacterium restricted from drug incorporation. Even if, recent findings reveal that M. tuberculosis develops biofilm in lesions of the human lungs [14]. Different non-tubercular Mycobacterium also displayed similar characteristics with M. tuberculosis. Therefore, non-tubercular Mycobacterium consider as a working model for drug discoveries. Furthermore, different experiments also revealed that organosulphur molecule in garlic clove, such as allicin or ajoene have imperative antimycobacterial effects and can even suppresses the growth of drug resistant mycobacterium [15]. However, these molecules are quite unstable and change into different compounds with time. Garlic oil contains different volatile substances. Therefore, volatile oil might overcome the problem as a useful antimycobacterial agent. There are almost 150 species of Mycobacterium that favors to surface adhesion and growth over aqueous suspension [16]. Its polymeric substances including lipid and polysaccharide that help to adhere surface wall with bacteria are called biofilm. Apparently, Mycobacterium develops strong biofilms on air-liquid interfaces [17,18]. Most importantly in biofilm, there is a heterogeneous population of bacteria which includes drug susceptible replicating bacteria, slow growing or non-replicating persistent bacteria that have different levels of phenotypic drug resistance [19]. Most importantly, recent studies have revealed that M. tuberculosis and M. smegmatis develop similar kinds of pelicular biofilm. Drug-resistant tuberculosis remains a challenging task to combat in the battle against tuberculosis. Therefore, new therapeutic strategies or drugs are need of the hour to combat battle against M. tuberculosis. According to garlic potential some of research studies revealed that volatile effect of garlic essential oil has effective antimicrobial activities and could be used as volatile antibiotic in combination with normal antibiotics [20]. Therefore, volatile effect of natural garlic essential oil might be helpful as an effective antimycobacterial agent. As per our comprehensive knowledge, no such apparent findings of anti-mycobacterial activity of GEO by vapor phase evaluation assay have been recorded. Thus, the goal of this study was to evaluate the efficacy of volatile and liquid usage of essential oil against M. smegmatis as a model organism. In addition, different M. tuberculosis strains including H37Rv, isoniazid (INH) resistant, and rifampicin (RIF) resistant clinical isolates were assessed with GEO for their susceptibility.
2. MATERIALS AND METHODS
2.1. Bacterial Strain and Culture Conditions
The non-tubercular bacterium used in this study, M. smegmatis mχ2 155 (ATCC14468), was initially procured from MTCC Chandigarh. M. tuberculosis H37Rv, one clinical isolates of isoniazid resistant and one rifampicin resistant isolate, was obtained from ICMR-Regional Medical Research Centre (RMRC), Bhubaneswar. All cultures were maintained in Middlebrook 7H9 broth medium with supplements to 10% oleic acid/bovine albumin, dextrose, catalase (OADC), 0.05% Tween 80, and 0.2% glycerol at 37°C for 48 h shaking incubation period for M. smegmatis and 15 days for M. tuberculosis. The bacteria cells containing 1 × 105 CFU/μL were maintained throughout this study for assessment of antimicrobial activities in liquid phase assay. Furthermore, other chemical reagents used in this study were obtained from HiMedia Pvt. Ltd. (Mumbai, India) and used as respective evaluation in vitro volatilization effects.
2.2. Herbal Collection and Extraction of Volatile Essential Oil
Commercially available garlic bulbs (Allium sativum (L.)) were procured from the local region of Chandrasekharpur market, Bhubaneswar, India at a longitudinal position of 20.3338° North, and 85.8241° East. Afterward, 300 g of fresh garlic bulbs were peeled out and crushed in a homogenizer mixture with double distilled water for further extraction of essential oil processes. Subsequently, homogenized garlic bulbs mixture was transferred to a round bottom flask and hydrodistillation procedures were initiated for 5 h at ambient temperature for the extraction of volatile essential oil from shredded garlic bulbs [21]. After that, the purified volatile oil was collected and distributed into separate vials for further investigation and analysis of anti-mycobacterial and anti-biofilm activities.
2.3. Assessment of Essential Oil Analysis Using Gas Chromatography-Mass Spectrometry (GC-MS) Equipment
Chemical analysis of volatile essential oil from garlic bulbs was performed using Clarus 580 GC coupled with SQ8S MS detector equipped with Elite-5 capillary column (30 m length × 0.25 mm I.D., film thickness 0.25 μm). Helium was used as a carrier gas and kept at a constant flow rate of 1 mL/min. The GC-MS was used under the following conditions: The oven temperature was first set at 60°C and subsequently increased to 220°C at a rate of 3°C/min; the electron ionization voltage was set at 70 eV, and the ion source temperature was set at 250°C. Following that, a series of carbon-n-alkanes (C8-C20) chains was used for calculating individual peak areas and side by side experimental retention index values reported in Satyal et al. (2017) literature and the NIST library were assessed for identification of volatile components from GC-MS analysis [22,23].
2.4. Assessment of Anti-Mycobacterial Effect of Garlic Essential Oil
Bacilli were grown to log phase, that is, 0.6–0.8 optical density at 600 nm and seeded 105 bacteria/well into a 96-well plate having serial dilution of garlic oil. Incubation was carried out at 37°C for 48 h for M.smegmatis and 10 days for M. tuberculosis. For minimum inhibitory concentration (MIC), 1X alamar blue (Invitrogen) per well was added and a change in color from blue to pink was recorded after 1 h of incubation for M. smegmatis and overnight for M. tuberculosis. Wells containing only media and bacteria served as positive control and wells having only media served as negative control. For minimum bactericidal concentration (MBC) of M. smegmatis, an appropriate dilution of each well was plated on 7H11 agar plates, incubated for 72 h at 37°C. Meanwhile, MIC and MBC tests were performed in triplicates and displayed as same interpreted result vales.
2.5. Activity of Garlic Essential Oil Vapor
To determine the fume effect of essential oil using inverted disc technique, M. smegmatis was initially cultured (7H9 medium with supplemented to OADC (10% W/V)) and allowed to grow to optical density of 0.8 at 600 nm (OD600) at 37°C. 105 bacterial cells were spread over 7H11 agar plate and a sterilized empty filter paper (6 mm) was infused with different concentrations of garlic oil ranging from 5–0.01 mg on the lid of the petri dish. The solidified agar plate containing bacteria was kept in inverted form and the bacterial growth inhibition was determined based on the fume effectives of GEO in between 48 and 72 h of incubation period at 37°C. The vapor experiment was executed in three independent triplicates and recorded to be same result.
2.6. Establishment of M. smegmatis Biofilm and Its Biomass Estimation
To evaluate the fume effect of GEO on biofilm and pellicle formation, mycobacteria (M. smegmatis) were grown in a specific 7H9 medium supplemented with OADC (10% W/V) for 36 h to reach an optical density (OD) of 0.7–1 at 600 nm. The mycobacterial culture was transferred to Sauton’s media at a ratio of 1:100–10 mL glass vials and added different concentrations (2–0.007 mg) of essential oil on the inner side of the cap of each vial for anti-biofilm outcomes. After that, the experimental vials were incubated for 5 days at 37°C and examined for each type of sub-population biomass using crystal violet (1%W/V) solution. Subsequently, the absorbance was taken at 592 nm using UV-visible spectrophotometer and the results were determined. Afterward, the same technique was repeated for 3 times and recorded as performed results in an excel sheet for further interpretation of analysis.
2.7. Statistical Interpretation
The MIC, MBC, and inverted disc fume tests were carried out in three replications and the result was found to be consistent. The percentage of biofilm inhibition at different volatile concentrations of GEO was examined using one-way ANOVA followed by Tukey’s post hoc multiple comparison test with IBM SPSS software version 26 and expressed as mean ± standard deviation at P < 0.05 significant level.
3. RESULTS
3.1. Phytochemical Composition of Essential Oil
The yield percentage of GEO obtained from hydrodistillation (Clevenger type apparatus) was noted to be 0.17% (v/w), on a dry weight basis. Following that, an extracted garlic clove essential oil was characterized using gas chromatography-mass spectrometry and identified volatile constituents in clove essential oil. GC-MS analyses revealed the major five volatile compounds accounting for 85.51% of total oil, including diallyl trisulfide (DTS) (37%), followed by diallyl disulfide (DDS) (25.9%), allyl methyl trisulfide (AMT) (13.16), allyl methyl disulfide (5.2%), and allyl (E)-1-propenyl disulfide (4.25%) as specified in [Table 1].
Table 1: Volatile constituents of essential oil from Allium sativum L. identified by GC-MS.
| S. No. | RT (min) | Compound | RIa | RIb | Obtained Area % from GC-MS |
|---|---|---|---|---|---|
| 1 | 5.172 | Allyl methyl disulphide | 912 | 916 | 5.2±0.01 |
| 2 | 10.412 | Diallyl disulphide | 1074 | 1080 | 25.9±0.02 |
| 3 | 11.082 | Allyl (E)-1-propenyl disulphide | 1095 | 1100 | 4.25±0.03 |
| 4 | 12.668 | Allyl methyl trisulfide | 1131 | 1138 | 13.16±0.01 |
| 5 | 19.643 | Diallyl trisulfide | 1295 | 1301 | 37.00±0.01 |
| Total | 85.51±0.08% |
a RI: Retention index calculated from homologous series n-alkane (C8–C20) using Elite-5 column.
b RI: Retention index from literature Satyal et al. (2017). GC-MS: Gas chromatography-mass spectrometry
Perhaps, it was fascinating to be noted that DTT, DDS, and AMT are abundantly identified in this essential oil and denoted as higher percentages of volatile sulfur compounds among other ingredients. As a result, DTT and DDS represents 62.9% of total essential oil and denoted as key highlight for abundant sulfur component present in essential oil.
3.2. Susceptibility Activity of Garlic Essential Oil
Initially, essential oil was synthesized through hydrodistillation technique, appeared to be thick yellow in color with a density of 1 g/mL (W/V). The extracted essential oil was further exploited to evaluate antimycobacterial activity against M. smegmatis using broth microdilution technique. Representative outcomes from the abovementioned strategies are illustrated in Figure 1. It shows that the MIC value of GEO at 0.03 mg/mL found to be effective with this efficient concentration. Consequently, it was also utilized for analyzing its bactericidal activity, which displayed that at a 0.5 mg/mL concentration level was sufficient to breakdown M. smegmatis growth development. Overall, garlic oil has a notable growth inhibitory and cidal effect against M. smegmatis.
 | Figure 1: In vitro growth effect of Mycobacterium smegmatis using garlic essential oil (a) minimum inhibitory concentration (MIC) in liquid phase, (b) minimum bactericidal concentration (MBC) in 7H11 agar medium, and (c) MIC and MBC representative values of garlic essential oil. [Click here to view] |
3.3. Effect of GEO Using Inverted Disc Technique
Considering the positive results obtained from antimicrobial activity of garlic essential oil, it was interesting to correlate these results in gaseous contact against M. smegmatis using an inverted disc volatilization assay. As disc volatilization technique is one of the fundamental experiment for evaluating the antimicrobial properties of essential oil in vapor-phase, as well as also used as a preliminary screening method to select the most promising oil [24]. Considering the above remark, our results reflect that there was dose dependent inhibitory activity of volatile GEO. The minimum inhibitory dose (MID) of essential oil in vapor concentration is 1 mg (1 μL), which was able to restrict the growth of M. smegmatis. However, below 1 mg (1 μL) of GEO showed growth of bacteria in plate but in a dose dependent manner [Figure 2].
| Figure 2: Volatile effect of garlic essential oil using inverted disc assay against Mycobacterium smegmatis strain. [Click here to view] |
3.4. Assessment of Anti-biofilm Effect Using Fume of GEO Against M. smegmatis
Due to their strong affinity toward abiotic materials such as, polyvinyl chloride or polycarbonate, mycobacterium thrive in environments with stress factors and form floating biofilms at air-liquid interface [25,26]. The carbon-nitrogen ratio in the nutritional medium can be a major consideration in mycobacterial coaggregation and biofilm development [26]. As efficient result was obtained from above inverted disc susceptibility examination, it was thought to be interesting to explore whether EO treatment through vapor contact had an effect on biofilm viability or not. As a result, to find out the mystery behind unknown facts of GEO efficacy, it was treated with M. smegmatis biofilm. Phenotypic observations showed that 0.06 mg (0.06 μL) GEO was enough to inhibit biofilm production by vapor phase contact. Crystal Violet estimation showed that 50% inhibition of GEO was observed at a concentration of 0.03 mg (0.03 μL) [Figure 3]. The activity of EO was found to reduce with decreasing concentrations (<0.06 mg), which promotes biofilm formation and biomass production on the surface of liquid media under ideal conditions (37°C). As a whole, M. smegmatis biofilm treated with GEO through vapor contact presented itself as a potential inhibitor of pellicle biofilm formation effectively.
 | Figure 3: Effect of air-liquid interface in eradication of NTB (Mycobacterium smegmatis) biofilm using volatilization assay. (a) Percentage of biofilm inhibition at different volatile concentration of garlic essential oil (GEO); data are presented as means (n = 3), error bars represent SD. *Indicates statically significant at P < 0.05. (b) Phenotypic observations of anti-biofilm activity using fume GEO. [Click here to view] |
3.5. Validation of the Effect of GEO on M. tuberculosis (H37Rv), INH and RIF Resistant Clinical Isolates
To confirm our observation found in M. smegmatis, we conducted a susceptibility test using garlic essential oil on H37Rv, the virulent strain of laboratory, as well as one isoniazid and one rifampicin resistant clinical isolate [Table 2]. The results indicate that MIC value of GEO at 0.003 mg/mL was determined to be lowest inhibitory dose against H37Rv virulent strain, followed by 0.06 mg/mL against INH resistance, and 0.03 mg/mL against RIF resistance strain. Looking with above considerable remark, it highlights that GEO is highly sensitive to H37Rv virulent strain as well as exhibits notable inhibitory activity against INH resistance and RIF resistance strains. Thus, the efficiency of essential oil was found to be quite effective against drug sensitive as well as drug resistant tuberculosis developing M. tuberculosis.
Table 2: Efficacy of garlic essential oil against different Mycobacterium tuberculosis strains.
| Tested microorganisms | MIC value (mg/mL) |
|---|---|
| Mycobacterium tuberculosis (H37Rv) | 0.003 |
| INH resistance | 0.06 |
| RIF resistance | 0.03 |
MIC: Minimum inhibitory concentration, INH: Isoniazid, RIF: Rifampicin
4. DISCUSSION
In the past few years, inhaling essential oils (EOs) vapor has gained rapidly with visions for a wide range of purposes, including adequate solutions for folk remedies and aromatherapy. Different studies also highlighted potential antimicrobial effects of essential oils in the literature, but very few number of studies have indicated an existing concern about antimicrobial activity of essential oil in vapor phase [11,24]. Indeed, the use of garlic is known for centuries to treat different infectious diseases. Different extraction procedures of garlic have been utilized for the evaluation of antibacterial activities against commensal pathogens and respiratory associated bacteria in infectious diseases. In addition, its essential oil demonstrated remarkable antibacterial activity against different enteric pathogens and commensal bacteria [3]. As a result, the above positive reports show that GEO is a promising antimicrobial agent along with antimicrobial drugs with a low risk of emergence of resistance in microbes.
The constituents of EO as well as their respective volatilities influence the properties of their vapors, which, in turn, promotes their antibacterial potential [25,26]. Different studied strains such as Escherichia coli, Penicillium corylophilum, Bacillus cereus, Listeria monocytogenes, Pseudomonas aeruginosa, Salmonella enteritidis, Staphylococcus aureus, Alternaria alternate, Ascophaera apis, Aspergillus niger, and Penicillium digitatum are quite susceptible to GEO (MIC ranges from 10–250 mL/L) using vapor of GEO with airtight disc volatilization techniques [10,11]. However, effect of garlic oil on any Mycobacterium spp. is not revealed. M. tuberculosis is one of the important pathogens and causes the second most highest death rate among different infectious diseases [15]. Recently, one of the reports from Reiter et al. states that the volatile substance of garlic extract, that is, allicin has antimicrobial activity against lung infection caused by Pseudomonas, Streptococcus, and Staphylococcus strains [20]. Regarding the use of garlic oil vapor, one hypothesis suggested that the vapor phase is more efficient because the lipophilic molecules present in the aqueous phase form micelles and so prevent the EOs from attaching to the organism, but the vapor phase allows for unfettered attachment [27]. Altogether, evidence of GEO in liquid phase has been extensively investigated, but its vapor potential remains relatively unexplored, which is now gaining interest in the medical field. A few studies have revealed that the vapor phase of garlic has anti-microbial effect [11] and concepts for the use of volatile antibiotic are slowly emerging. Furthermore, no preceding evidence for GEO anti-mycobacterial activity in liquid and vapor phase has been discovered. Therefore, we decided to explore the effectiveness of GEO against M. smegmatis using MIC, MBC, and inverted disc volatilization and anti-biofilm assay by vapor interaction approaches. Furthermore, we confirmed that GEO restricted the growth of M. tuberculosis.
In the present study, we have chosen fast growing M. smegmatis as a model organism in our experiment. It shows for the first time the anti-mycobacterial potential of GEO against M. smegmatis and represents that essential oil has direct effect on tested strain. While Figure 1 illustrates MIC value of essential oil (GEO), at 0.03 mg/mL with MBC value, at 0.5 mg/mL are found to be effective as both growth inhibitors as well as bactericidal. Furthermore, for the proof of the concept, we have performed the antimicrobial susceptibility test of M. tuberculosis virulent strain H37Rv and one each of INH and RIF resistant clinical isolates and found that GEO was able to restrict the growth of all the virulent strains [Table 2]. In contrast to the above findings in liquid phase, GEO by gaseous contact is evident with an effective antimicrobial action against M. smegmatis with good solubility and diffusibility rate of active compounds contained in garlic essential oil, as depicted in Figure 2. The volatile substance of 1 mg garlic oil restricted the bacterial growth and it works in dose dependent manner. As the, antimicrobial drug resistance results in more pathogenicity and virulence factors in mycobacterial infections, an effective approach is required to combat the rapid progress of the disease. Consequently, biofilms contain a heterogeneous population of replicating and non-replicating persistent bacteria [14]. Moreover, biofilm model was found to be an ideal way to execute and evaluate the effector doses of anti-tubercular drugs against mycolic acid produced by the-pathogens [28,29]. Considering the above proclamation, we found that GEO in the vapor phase exhibited bactericidal potential on M. smegmatis biofilm at a dose of 0.25 mg of GEO. While at the lowermost concentration, 0.03 mg MID dose of essential oil performs 50% of inhibition against biofilm formation in M. smegmatis strain. Altogether, vapor phase of GEO delivers a potential mark for inhibitory agent against M. smegmatis biofilm.
In brief, our findings support the anti-microbial action of GEO by vapor contact and it was found to be more efficient when it was exposed to high vapor concentration for a short period of time. In addition, the results also suggested that at a maximal vapor level of 0.1 mg GEO is quite enough to prevent normal inhibition of biofilm forming M. smegmatis strain as well as 1 mg (inverted disc vaporization concentration) GEO efficiently prevented the replicating M. smegmatis [Figure 3].
From the previous literature surveys, it was perceived that in GEO the percentage of DTS and DDS were found to be high, which can be considered as a probable cause of essential oil’s antibacterial property. In addition, its sulfur containing compounds such as DDS and DATS make GEO highly fragrant and make essential volatile components in garlic oil a novel source of antimicrobial therapy [15,30]. Notably, our GC/MS analysis also showed similar types of active volatile constituents [Table 1] and resembles novel sources of remarkable therapy for all of the above tested activities. Thus, GEO vapor therapy can be useful in anti-mycobacterial activity. Although we have done these experiments in M. smegmatis as a model organism, these data suggest that use of vapor phase garlic oil could restrict M. tuberculosis (H37Rv) and its drug resistant form.
5. CONCLUSION
As garlic bulbs have been well known to possess antibacterial properties from ancient civilization times, it makes considerable interest among researchers and found to be one of the most effective approaches to combating antibiotic resistance strains of pathogenic bacteria. Its organosulfur compounds make more appealing in the direction of bactericidal effects through multiple mechanisms and signifies difficult for bacteria to develop resistance. Furthermore, GEO is found to be effective against some other clinical pathogens using vapor phase method, but it has not been examined against any Mycobacterial spp. In view of the rapid rise of antibiotic resistance in TB disease, it is necessary to evaluate the efficacy of essential oil, to know its utilization in vapor phase with desire effect. On contrary, the findings of these results suggest that GEO exhibits remarkable anti-mycobacterial activity in vapor phase, which attributes the presence of organosulfur mixtures causes a potent antimicrobial effect on M. smegmatis and M. tuberculosis strains. Furthermore, the potential effectiveness of vapor phase through inverted disc and anti-biofilm effect by volatilization approaches shows that it could be a potential source of growth inhibitor in mycobacterial biofilm. Therefore, GEO vapor could be used as a vapor antibiotic and might be used with normal antibiotics as combination therapy mainly for different pulmonary diseases. Although tuberculosis is one of the deadliest pulmonary diseases, this strategy could be a new stratagem to eliminate the tubercular pathogen faster from human civilization.
6. ACKNOWLEDGEMENTS
We acknowledge SOA Deemed to be University and ICMR-Regional Medical Research Centre (RMRC), Bhubaneswar for providing the facility and space to do the work.
7. AUTHORS’ CONTRIBUTIONS
Ashirbad Sarangi and Bhabani Shankar Das helped in conceptualization, data curation, formal analysis, validation, writing, and editing of the manuscript. Ambika Kumar Sahoo, Sunil Swick Rout, Sidhartha Giri helped in investigation, validation, visualization, and writing and editing of the manuscript. Debapriya Bhattacharya generate the idea designed, wrote and edited the manuscript.
8. FUNDING
This work was supported by the grant provided to Dr. Debapriya Bhattacharya from SERB, Government of India.
9. CONFLICT OF INTEREST
The authors have declared that there is no conflict of interests exist regarding the publication of this paper.
10. ETHICAL APPROVAL
Institutional ethical approval was taken from the ethics committee.
11. DATA AVAILABILITY
All data generated and analyzed are included within this research article.
12. PUBLISHER’S NOTE
This journal remains neutral with regard to jurisdictional claims in published institutional affiliation.
REFERENCES
1. Guercio V, Galeone C, Turati F, La Vecchia C. Gastric cancer and allium vegetable intake:A critical review of the experimental and epidemiologic evidence. Nutr Cancer 2014;66:757-73. [CrossRef]
2. Block E. The chemistry of garlic and onions. Sci Am 1985;252:114-9. [CrossRef]
3. Bhatwalkar SB, Mondal R, Krishna SB, Adam JK, Govender P, Anupam R. Antibacterial properties of organosulfur compounds of garlic (Allium sativum). Front Microbiol 2021;12:613077. [CrossRef]
4. Charron CS, Milner JA, Novotny JA. Garlic. In:Caballero B, Finglas PM, ToldráF, editors. Encyclopedia of Food and Health. Oxford:Academic Press;2016. 184-90. [CrossRef]
5. Trio PZ, You S, He X, He J, Sakao K, Hou DX. Chemopreventive functions and molecular mechanisms of garlic organosulfur compounds. Food Funct 2014;5:833-44. [CrossRef]
6. Demirci B, Yusufoglu HS, Tabanca N, Temel HE, Bernier UR, Agramonte NM, et al. Rhanterium epapposum Oliv. Essential oil:Chemical composition and antimicrobial, insect-repellent and anticholinesterase activities. Saudi Pharm J 2017;25:703-8. [CrossRef]
7. Chouhan S, Sharma K, Guleria S. Antimicrobial activity of some essential oils-present status and future perspectives. Medicines (Basel) 2017;4:58. [CrossRef]
8. Orchard A, Viljoen A, Van Vuuren S. Antimicrobial essential oil combinations to combat foot odour. Planta Med 2018;84:662-73. [CrossRef]
9. Laird K, Phillips C. Vapour phase:A potential future use for essential oils as antimicrobials?Lett Appl Microbiol 2012;54:169-74. [CrossRef]
10. Ko JW, Jeong SH, Kwon HJ, Shin NR, Seo YS, Kim JC, et al. Preventive effect of garlic oil and its organosulfur component diallyl-disulfide on cigarette smoke-induced airway inflammation in mice. Nutrients 2018;10:1659. [CrossRef]
11. Houdkova M, Kokoska L. Volatile antimicrobial agents and in vitro methods for evaluating their activity in the vapour phase:A review. Planta Med 2020;86:822-57. [CrossRef]
12. Hutchings MI, Truman AW, Wilkinson B. Antibiotics:Past, present and future. Curr Opin Microbiol 2019;51:72-80. [CrossRef]
13. Goletti D, Delogu G, Matteelli A, Migliori GB. The role of IGRA in the diagnosis of tuberculosis infection, differentiating from active tuberculosis, and decision making for initiating treatment or preventive therapy of tuberculosis infection. Int J Infect Dis 2022:S1201-9712:00126-6. [CrossRef]
14. Ojha AK, Baughn AD, Sambandan D, Hsu T, Trivelli X, Guerardel Y, et al. Growth of Mycobacterium tuberculosis biofilms containing free mycolic acids and harbouring drug-tolerant bacteria. Mol Microbiol 2008;69:164-74. [CrossRef]
15. Sarangi A, Das BS, Patnaik G, Sarkar S, Debnath M, Mohan M, et al. Potent anti-mycobacterial and immunomodulatory activity of some bioactive molecules of Indian ethnomedicinal plants that have the potential to enter in TB management. J Appl Microbiol 2021;131:1578-99. [CrossRef]
16. Mullis SN, Falkinham JO, 3rd. Adherence and biofilm formation of Mycobacterium avium, Mycobacterium intracellulare and Mycobacterium abscessus to household plumbing materials. J Appl Microbiol 2013;115:908-14. [CrossRef]
17. Carter G, Wu M, Drummond DC, Bermudez LE. Characterization of biofilm formation by clinical isolates of Mycobacterium avium. J Med Microbiol 2003;52:747-52. [CrossRef]
18. SochorováZ, Petrá?kováD, Sita?ováB, BuriánkováK, BezouškováS, Benada O, et al. Morphological and proteomic analysis of early stage air-liquid interface biofilm formation in Mycobacterium smegmatis. Microbiology (Reading) 2014;160:1346-56. [CrossRef]
19. Lebeaux D, Ghigo JM, Beloin C. Biofilm-related infections:Bridging the gap between clinical management and fundamental aspects of recalcitrance toward antibiotics. Microbiol Mol Biol Rev 2014;78:510-43. [CrossRef]
20. Reiter J, Levina N, Van der Linden M, Gruhlke M, Martin C, Slusarenko AJ. Diallylthiosulfinate (Allicin), a volatile antimicrobial from garlic (Allium sativum), kills human lung pathogenic bacteria, including MDR strains, as a Vapor. Molecules 2017;22:1711. [CrossRef]
21. Wang YH, Zhang YR. Variations in compositions and antioxidant activities of essential oils from leaves of Luodian Blumea balsamifera from different harvest times in China. PLoS One 2020;15:e0234661. [CrossRef]
22. Satyal P, Craft JD, Dosoky NS, Setzer WN. The chemical compositions of the volatile oils of garlic (Allium sativum) and wild garlic (Allium vineale). Foods 2017;6:63. [CrossRef]
23. Gecibesler IH, Behcet L, Erdogan MK, Askin H. Antioxidant potencies and chemical compositions of essential oils of two endemic species grow in Turkey:Astragalus oocephalus subsp stachyophorus and Astragalus sericans. Prog Nutr 2017;19:60-7.
24. El Omari K, Hamze M, Alwan S, Osman M, Jama C, Chihib NE. In-vitro evaluation of the antibacterial activity of the essential oils of Micromeria Barbata, Eucalyptus globulus and Juniperus excelsa against strains of Mycobacterium tuberculosis (including MDR), Mycobacterium kansasii and Mycobacterium gordonae. J Infect Public Health 2019;12:615-8. [CrossRef]
25. Burt S. Essential oils:Their antibacterial properties and potential applications in foods-a review. Int J Food Microbiol 2004;94:223-53. [CrossRef]
26. Tullio V, Nostro A, Mandras N, Dugo P, Banche G, Cannatelli MA, et al. Antifungal activity of essential oils against filamentous fungi determined by broth microdilution and vapour contact methods. J Appl Microbiol 2007;102:1544-50. [CrossRef]
27. Nadjib BM, Amine FM, Abdelkrim K, Fairouz S, Maamar M. Liquid and vapour phase antibacterial activity of Eucalyptus globulus essential oil=susceptibility of selected respiratory tract pathogens. Am J Infect Dis 2014;10:105-17. [CrossRef]
28. AlChalabi R, Mohammed R, Adnan R, Al-Bayati S. The antibacterial effect of ethanolic extract of Allium sativum on biofilm forming Staphylococcus aureus which cause folliculitis. Int J Adv Res 2017;5:1175-82. [CrossRef]
29. Tewari A, Jain B, Dhamannapatil P, Saxena M. Biofilm resistance to antimicrobial agents and novel approaches to combat biofilm mediated resistance in bacteria. EC Microbiology 2018;3:71-7.
30. Janatova A, Bernardos A, Smid J, Frankovaa A, Lhotkac M, KourimskáL, et al. Long-term antifungal activity of volatile essential oil components released from mesoporous silica materials. Ind Crops Prod 2015;67:216-20. [CrossRef]